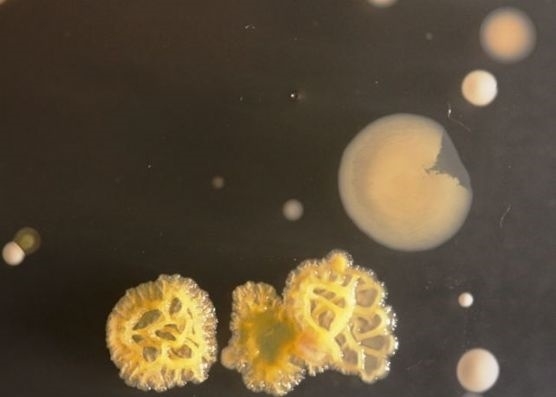
Cep telefonu kullananlar dikkat! galerisi resim 2

Cep telefonu kullananlar dikkat!
01 Nisan 2016 Cuma 15:08İnanması zor ama cep telefonlarında tuvaletin 18 katı daha fazla bakteri bulundu. Öğrenciler, bakterileri laboratuvarlarda ürettiler ve geliştirdiler. Cep telefonunu bakteri üretme kaplarına koyan öğrenciler, 3 gün sonra bu garip yaratıkları görüntülediler. Üniversiteden Doktor Simon Park, cep telefonlarının sadece iletişim aracı olmadığını, bizim kişisel izlerimizi de taşıdığını söylüyor. Tabii aynı zamanda yediklerimizi, içtiklerimizi de telefonlara bir şekilde bulaştırıyoruz.
Tüm Hakları Saklıdır © 2014 Haberdarım | İzinsiz ve kaynak gösterilmeden yayınlanamaz.
Haber Yazılımı: So Bilişim
Haber Yazılımı: So Bilişim